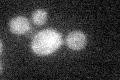
YLR097C
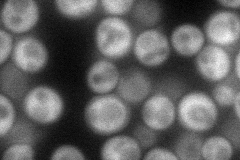
YLR097C
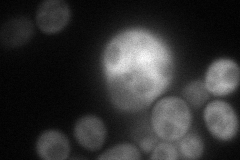
YLR097C
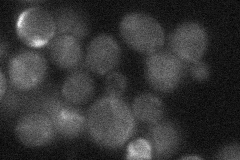
YLR097C

View description
Putative SCF-ubiquitin ligase F-box protein, based on both genetic and physical interactions and sequence similarity; identified in association with Cdc53p, Skp1p and Ubi4 in large and small-scale studies
Localization:
Intensity:
Fold change:
Significance:
-
C’ GFP library in SD
below threshold14.17 -
N' NOP1pr-GFP in SD
cytosol73.5949 -
N' TEF2pr-mCherry in SD
cytosol80.8261 -
N' NATIVEpr-GFP in SD
mitochondria21.3158 -
N' TEF2pr-VC and Cyto-VN in SD

cytosol36.152 -
C’ GFP library in SD+DTT

cytosol15.511.09No -
C’ GFP library in SD+H2O2

cytosol17.081.2No -
C’ GFP library in Starvation Media

cytosol17.631.24No -
C’ GFP library on the background of Pup2-DaMP

below threshold -
C’ GFP library on the background of CCT mutant

below threshold18.16431.28079No
